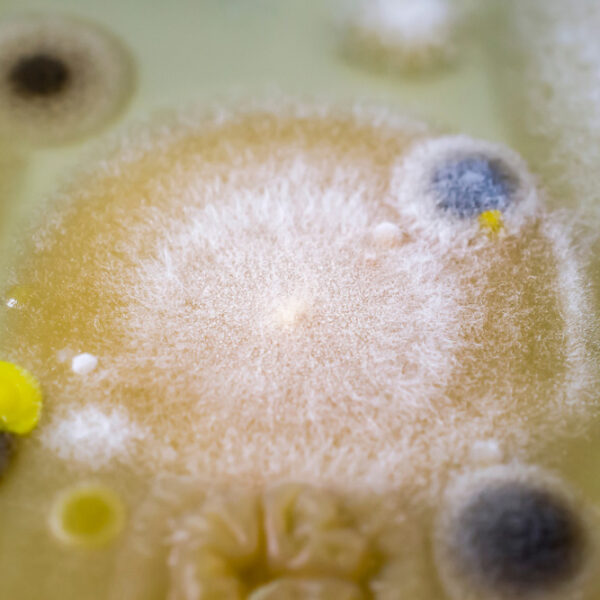
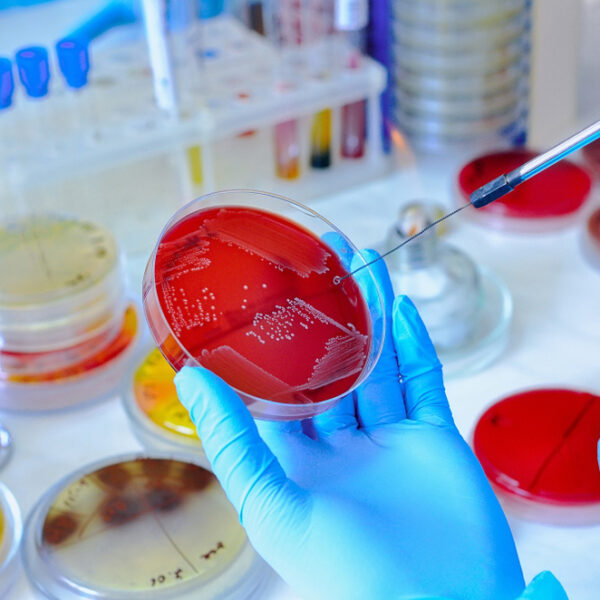

About US SECURE VISION
for Food and Water Safety and Quality
CONFIDENTIALITY AND IMPARTIALITY
General management in Secure Vision is committed to ensure impartiality by focusing on the needs and requirements of customers and by identify risks that arise from its activities and from the relationships of its personnel, Actions to address risks and opportunities written. Any information obtained from any sources related to specific customer/s, will be treated as confidential between the customer/s and secure vision .
STAFF COMPETENCY
Secure Vision Laboratory Staff have the knowledge, skills, and abilities to perform required duties. Competence is based on education, experience, demonstrated skills, and training. In addition, all technical staff undergoes to frequently test, and proficiency test to ensure the validity of results and staff competency.

Our Lab Culture:
Secure Vision for Food Safety and Quality Lab, have a new mentality and vision to protect, save lives and business. We work with food & water manufacturers and food services providers to ensure the sanitation of production facilities through environmental monitoring programs. We believe in the power to come together and make real progress in the ever changing world of food, water and environment safety and Quality. So we’ll continue to build on our unrivalled market presence, playing our part to help everyone connected to food, water, and environment safety and quality, to make real progress and deeper experiences together.

1. Impartiality & Confidentiality
– All employees in Secure vision Lab are required to sign statement declaring that they have been informed on the rules of impartiality and confidentiality of all information obtained or created during the performance of laboratory activities.
And not to be undergo to any kind of internal or external pressure which may influence the technical integrity.
– The access to laboratory is controlled by identifying the allowed persons (employees) to enter; furthermore other people can enter to laboratory by the acceptance from general Manager.
– Any third-party information will only share with the customer/s if the source of the information provides agreement to do so.
2. Equality
We are dedicated to creating balanced, inclusive work environments for all Customers, regardless of race, gender, sexual orientation, identity or experience.
3. Sustainability
Secure vision employees are committed to ethical, sustainable practice in the office, at our shows, and in their volunteer commitments among suppliers, our customers
4. Development
WHY OUR LAB NOT OTHER…
Our competitive advantage
- Secure vision laboratory is a center has ISO 17025:2017 accreditation certificate.
- high competences and professional staff.
- Using accurate and calibrated Equipment, with frequently checked.
- Perform testing, calibration, verification and validation of method
- All the methods which used in Secure Vision Lab are latest valid version standard and referenced methods.
- Secure Vision Lab the Only Lab is accredited in three sampling methods (Food Sampling, Water Sampling , Cosmetics Sampling ,Chemical Sampling and Surface Swab).
- providing consulting and training
- High quality and Low price
Client Service
Good communication
Organizational and clerical
80Medical knowledge
95Customer service
87
See what said our Patient and Visitors
Our goal is your complete health and wellness

"My experience at West Hills Hospital was superior and well above medical treatment standards. The physicians, nurses and staff successfully eradicated (my disease) with unbelievable care and compassion. Their attention to ensuring my well-being was exceptional."

"I have learned a great deal from Dr Post about the management of patients with anterior knee pain and/or patellar instability. I have never seen a more thoughtful and organized physician who considers each patient as an individual. I am grateful to call Dr Xtra a colleague."

"I would like to make it clear, that the good people of Morgantown, and indeed all of West Virginia have a genuine World Class orthopedic surgeon in their midst. I have known Dr. Xtra for over 2 decades, and have seen and interacted with him at many national, and international conferences on the knee."
Our Clients